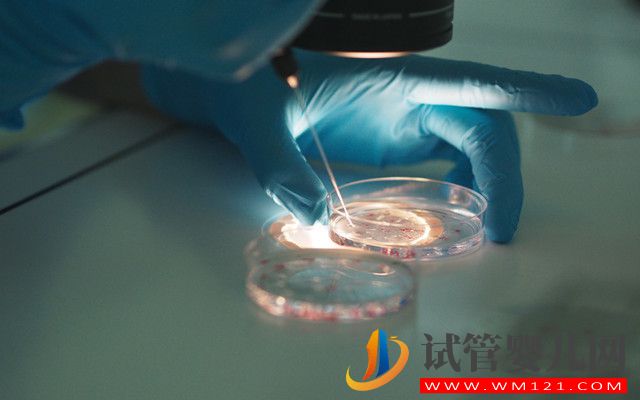
泰國試管嬰兒中介排名(圖2)

泰國試管嬰兒中介排名
試管嬰兒網(wǎng)目前泰國試管中介的質(zhì)量是參差不齊的,特別是最近這幾年泰國試管嬰兒中介的數(shù)量劇增,數(shù)量急劇增加的背后,不僅僅是加大了市場競爭,也帶來了一定的負(fù)面影響,比如監(jiān)管缺乏的背后,使得國內(nèi)海外試管服務(wù)機(jī)構(gòu)質(zhì)量參差不齊,海外就醫(yī)亂象滋生,各類,陷阱問題增多,那么如何選擇一個(gè)好的中介機(jī)構(gòu)就非常重要了!今天,就來看下2022年泰國試管中介最新排名。

在了解泰國試管中介排名之前,我們先來了解一下泰國試管中介排名主要看哪些指標(biāo):
1、成功案例數(shù)
我們通過中介試管嬰兒網(wǎng)公司服務(wù)成功案例的多少可以看出一個(gè)公司的影響力。有的小中介公司一個(gè)月甚至一年的成功案例都寥寥無幾,這樣的公司可想而知。一般來說,服務(wù)的成功案例數(shù)一般與公司規(guī)模和影響力是成正比的。
2、中介公司的規(guī)模
公司規(guī)模的話是可以實(shí)地考察的,通過對(duì)公司的實(shí)地了解,才能看出公司的實(shí)力。
3、中介公司從業(yè)的經(jīng)驗(yàn)
由于泰國試管嬰兒越來越受到國人的青睞,很多的中介公司紛紛興起,這些公司規(guī)模小,項(xiàng)目服務(wù)不成熟,難以和大公司相比。
4、服務(wù)項(xiàng)目是否全面
市場上很多的中介試管嬰兒網(wǎng)公司只提供醫(yī)療翻譯等少項(xiàng)服務(wù)項(xiàng)目,服務(wù)項(xiàng)目缺少一項(xiàng)都有可能讓國內(nèi)患者在泰國就醫(yī)造成很大的困擾,一般來說,泰國試管就醫(yī)流程主要包括檢查備孕、機(jī)票、簽證、住宿、飲食、交通、醫(yī)院預(yù)約、翻譯、專車接送、孕期跟蹤與服務(wù)咨詢等等,這可以作為尋找中介公司的一大標(biāo)準(zhǔn)。
小貼士:目前很多的泰國試管中介胡亂吹噓自己的公司多么龐大,公司的創(chuàng)立長達(dá)多少年,成功案例達(dá)多少起,只要你稍去調(diào)查,公司就會(huì)暴露無疑。其實(shí)這只是一些中介夸大宣傳、誘導(dǎo)患者的不良手段。如果想要了解泰國試管中介的排名,還需要患者去仔細(xì)比對(duì)和調(diào)查,心中自然會(huì)有數(shù),哪些中介公司可以選擇,哪些不可以選擇。





